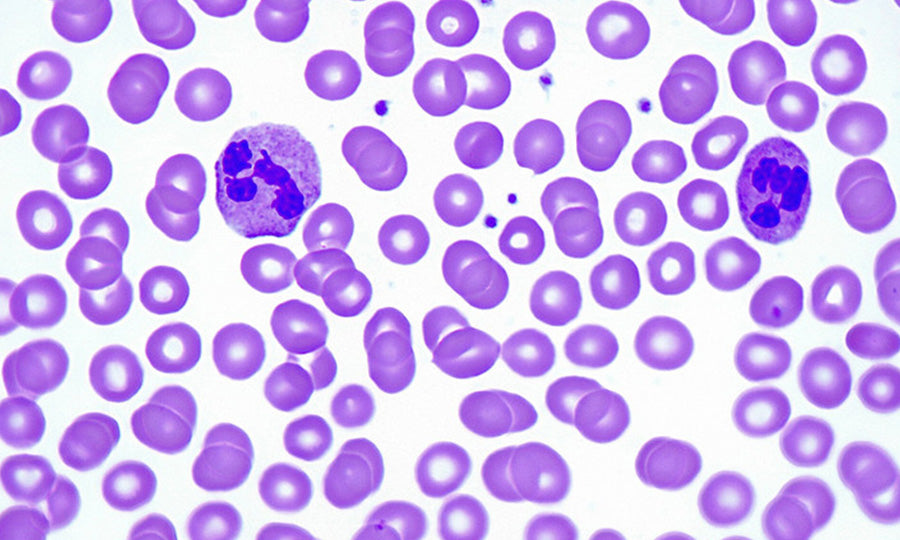

Microcosm
-

Chemical reaction products
-

Coin*1757
-

Coin*1864
-

Coatings and films
-

Plant tissues
-

Cell structure
-

Drug particles
-

Blood cells
-

Microorganisms
-

Nanomaterials
-

Diamond crystal
-

Circuit board
-

Onion epidermal cells
-

Mechanical watches
-

Pollen
-

Pumpkin stem
1
/
of
16